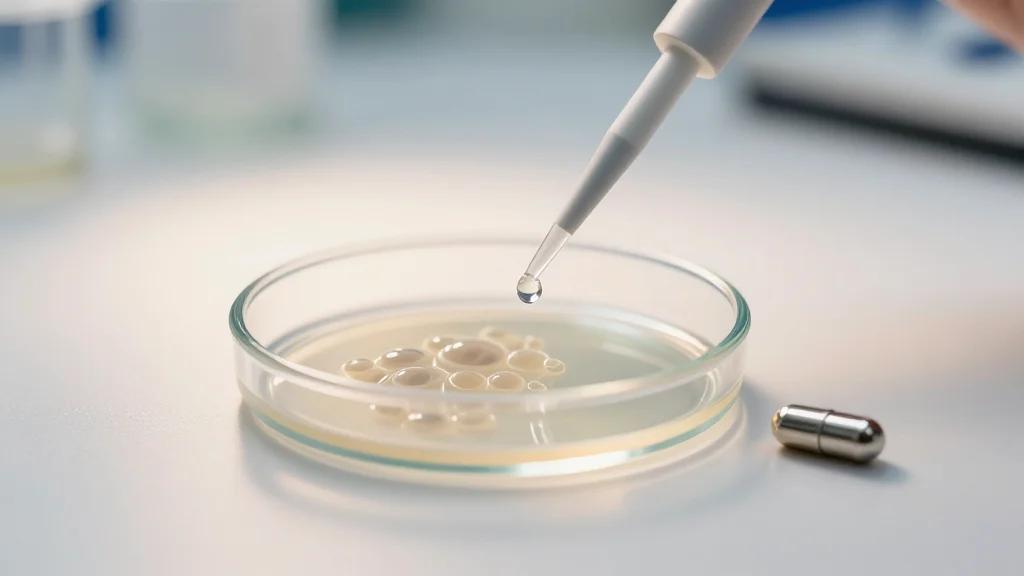
Stocks Showing Rising Market Leadership: MoonLake Immunotherap Earns 85 RS Rating

ASX Edges Higher as Fragile Ceasefire Tests Investor Optimism
Australia’s ASX200 edged up 0.2% to 8,973 points on Thursday as oil prices recovered and energy and financial stocks provided support. The market’s modest gain came amid a fragile US‑Iran cease‑fire, with the Strait of Hormuz still partially closed, keeping investors cautious. Woodside and Santos rose on higher crude, while Bendigo Bank surged on a strong trading update. Conversely, tech names such as WiseTech and Xero fell sharply, reflecting sector‑specific pressure.

Piero Cipollone: The Digital Euro - Preparing for a Potential Launch
Eurozone leaders reaffirmed the strategic importance of a digital euro, linking it to monetary sovereignty, reduced retail‑payment fragmentation, and Single Market resilience. The Eurosystem is advancing technical preparations but will only issue the token‑based currency after a dedicated legal framework...

Record DII Buying Marks Renewed Domestic Confidence
In a month eclipsed by bad news, we have seen record DII buying in March 2026. The last time this happened was March 2020. COVID saw DIIs or retail investors, if we might call them, come out leg and toe...

Chokepoint in the Gulf: What the US-Israeli War on Iran Means for Southeast Asia’s Food Security
The US‑Israel war on Iran has choked Gulf energy and fertilizer supply chains, locking up roughly 20‑30% of global oil and LNG and a third of traded fertilizers. Prices for nitrogenous fertilizers have surged over 50% since the start of...

Nifty-Gold Ratio Rises to 1.57: What Does This Mean for Stock Market Investors?
The Nifty‑Gold ratio climbed to 1.57, up from 1.5 last week, as the Nifty 50 rallied over 1,650 points in early April while gold prices stayed volatile. A ratio below 2.5 historically precedes equity upside, suggesting Indian stocks may outpace...

Gold Exports Fetch US$278.5 Million in February as Deliveries Surge
Zimbabwe’s gold export earnings jumped to US$278.5 million in February 2026, a 138% increase over the same month a year earlier. The surge was driven by a sharp rise in deliveries from the artisanal and small‑scale mining (ASM) sector, which supplied...

Made $200k on USDCAD with Simple Bullish Impulse Setup
I still look back at this setup I made $200k trading On USDCAD which was a record month for me trading in terms of gains obviously. It was a simple bullish impulse structure setup Watch the breakdown and recap here https://youtu.be/jlAr5hdXLc0?si=TSGu9_2ivAhZZf0G

Gabriel Makhlouf: Inflation, Growth, and Monetary Policy in a Fractured World
Gabriel Makhlouf, the ECB’s chief economist, warned that the ongoing Middle‑East conflict is creating a deep energy supply shock that could push oil to $145 per barrel and keep euro‑area inflation above the 2 % target through 2027. He outlined three...

How Do You Plan to Fund Your Retirement?
The Real Agriculture blog asks farmers how they intend to finance their retirement, highlighting a cultural reluctance to discuss the topic. While some producers have detailed plans, many lack a concrete strategy and risk financial insecurity in later years. The...

Uniqlo Owner Fast Retailing Books 29.4% Rise in Q2 Profit, Raises Forecast
Fast Retailing, the parent of Uniqlo, reported a 29.4% jump in Q2 operating profit to ¥189.8 bn (≈$1.19 bn), beating analysts’ expectations. The company lifted its full‑year profit target to ¥700 bn (≈$4.4 bn), positioning it for a fifth straight year of record earnings....

Luis De Guindos: Navigating Turbulence - Challenges for Europe and the Path Ahead
Luis de Guindos warned that Europe faces heightened geopolitical uncertainty, especially from the Middle‑East war, which threatens energy prices and financial stability. He noted the euro area grew 1.5% in 2025 and inflation has hovered near the ECB’s 2% target,...

This Newly-Listed Stock Finds No Buyer After Its Debut on Dalal Street, Hits Lower Circuit for Fifth Day in a...
Amir Chand Jagdish Kumar (Exports) Ltd’s shares opened weakly on April 2 and have since triggered the 5% lower circuit for five consecutive sessions, sinking roughly 43% from the IPO price. The stock opened at a discount on both BSE and...

Monthly Index News: March 2026
In March 2026 energy stocks led the market, with the STOXX Europe 600 Energy index up 14.6% in euros and the STOXX Global 1800 Energy index rising 10.2% in dollars as Brent crude breached $110 per barrel following Iran’s blockade...

Delta’s CEO Spent 15 Years Turning the Airline Into a Premium Brand. Now It Commands 20% More per Seat than...
Delta Air Lines CEO Ed Bastian’s 15‑year push to de‑commoditize the carrier is now delivering roughly 20% higher revenue per seat than rivals. Premium cabin revenue reached $5.4 billion in Q1, just $41 million short of main‑cabin earnings, and is set to...

Macquarie Boosts 2026 Nickel Forecast Amid Tight Indonesian Supply
Macquarie raised its 2026 nickel forecast as Indonesia ore tightness and slower supply growth tighten market balance. https://www.metalnomist.com/2026/04/macquarie-nickel-price-outlook-turns.html

Feedgrain Focus: Dry North Lifts Values, South Softens
Dry conditions in northern Australia have forced growers to hold back wheat and barley, lifting new‑crop prices to about $425 AUD per tonne (≈$280 USD). In contrast, southern regions are seeing softer grain values as limited export demand, a urea shortage and...

Mark Cooper on Global Small Cap Value, AI and Managing Small Cap Long/Short at MAC Alpha | S08 E13
Mark Cooper joins The Acquirers After Hours podcast to discuss his approach to global small‑cap value investing, the role of artificial intelligence in stock selection, and the mechanics of managing a small‑cap long/short portfolio at MAC Alpha. He outlines how...

WTI Crude Plummets 13% in One Day, Biggest Since 1986
WTI Crude is down over 13% in a single day. One of the largest declines since 1986.

PVH Scores Relative Strength Rating Upgrade; Hits Key Threshold
PVH Corp., the parent of Calvin Klein, saw its Relative Strength rating climb from 80 to 84 after reporting a Q4 earnings rebound. Earnings per share swung from a 7% decline to a 17% gain, while revenue rose 6% year‑over‑year....

IBD Rating Upgrades: Monster Beverage Shows Improved Relative Price Strength
Monster Beverage's Relative Strength Rating rose from 70 to 73, signaling improved technical momentum. The stock cleared a 66.75 buy point in a first‑stage flat base and is now considered extended, out of the buy range. EPS growth slowed to...

Stocks Showing Improving Market Leadership: Ferguson Enterprises Earns 81 RS Rating
Ferguson Enterprises’ Relative Strength (RS) rating jumped from 78 to 81, placing the stock in the top percentile of price momentum. The company reported 12% earnings‑per‑share growth despite a 6% decline in sales, and it is forming a cup‑without‑handle pattern...

Jackson Financial Sees IBD RS Rating Rise To 73
Jackson Financial (JXN) saw its Investor’s Business Daily Relative Strength rating climb from 70 to 73, indicating modest price momentum over the past year. The rating, which measures a stock’s performance against the IBD database, remains below the 80‑plus level...

Stocks With Rising Relative Strength: Crown Holdings
Crown Holdings (CCK) saw its Investor's Business Daily Relative Strength rating climb from 61 to 72, signaling stronger price momentum over the past year. While earnings growth decelerated to 9% from 13%, revenue growth accelerated to 8% from 4% in...

After Ceasefire Rally, Focus Turns to Inflation
The Schwab Market Update highlighted how a temporary ceasefire in the Middle East is shifting market focus back to inflation and economic data, while noting that shipping disruptions and fragile peace keep risks alive. Key data points include the upcoming...

PG&E Reaches 80-Plus Relative Strength Rating Benchmark
Pacific Gas & Electric (PG&E) saw its Investor's Business Daily Relative Strength Rating rise from 76 to 81, breaching the coveted 80‑plus threshold that signals strong price momentum. The utility posted a 16% earnings jump and 3% sales growth in...

IBD Rating Upgrades: Gates Industrial Flashes Improved Price Strength
Gates Industrial (GTES) saw its IBD Relative Strength Rating climb from 61 to 73, indicating improving price momentum over the past year. The company reported 6% earnings‑per‑share growth and 3% sales growth in its latest quarter. It currently ranks 14th...

Stocks Generating Improved Relative Strength: InterContinental Htls ADR
InterContinental Hotels Group’s ADR saw its Investor's Business Daily Relative Strength rating climb from 70 to 77, indicating stronger price momentum relative to the market. The stock is forming a cup‑without‑handle pattern near a $150.89 entry point, with a breakout...

Kontoor Brands Earns IBD Rating Upgrade
Kontoor Brands saw its Investor’s Business Daily Relative Strength rating climb from 61 to 73, moving the stock closer to the coveted 80‑point benchmark that often precedes major price rallies. The company reported a 25% surge in quarterly earnings and...

OSI Systems Meets 80-Plus Relative Strength Rating Benchmark
OSI Systems' IBD SmartSelect Composite Rating rose to 96, up from 94, while its Relative Strength Rating jumped to 82, entering the 80‑plus percentile. The company posted 7% earnings growth and 11% sales growth in the latest quarter. It is...
Stocks Showing Rising Market Leadership: MoonLake Immunotherap Earns 85 RS Rating
MoonLake Immunotherapeutics (MLTX) saw its shares surge after the company signaled alignment with the FDA on a development path for its skin‑disease drug. The stock’s Relative Strength Rating jumped from 79 to 85, crossing the 80 threshold that historically precedes...

Ball Corp Earns Relative Strength Rating Upgrade; Hits Key Threshold
Ball Corp’s Relative Strength (RS) Rating jumped from 78 to 82, breaking the critical 80‑plus threshold that historically signals early‑stage market leadership. The move places the metal‑packaging firm at the 82nd percentile of price performance over the past 52 weeks....

Stocks Showing Rising Market Leadership: Kingsoft Cloud ADR Earns 84 RS Rating
Kingsoft Cloud ADR’s Relative Strength rating jumped from 77 to 84, signaling strong market momentum. The stock is charting a cup‑without‑handle pattern with a $17.79 entry target and requires a breakout volume 40% above average. Quarterly sales rose 29% while...

I'm an Energy Expert and This Is What Those on Heating Oil Can Do to Beat Price Gouging
Heating oil powers about 5% of UK homes (≈1.6 million households) and price spikes from geopolitical tensions have left many owners scrambling for cheaper heat. Energy specialist David Hilton outlines a range of tactics—from low‑cost motorised radiator valves to full‑scale heat‑pump...

XP Scores Relative Strength Rating Upgrade; Hits Key Benchmark
XP’s Relative Strength (RS) Rating jumped from 78 to 83, breaching the critical 80 mark that often precedes strong uptrends. The broker‑dealer reported earnings accelerating to 28% year‑over‑year, up from 15% in the previous quarter, while revenue surged to 26%...

Ametek Scores Relative Strength Rating Upgrade; Hits Key Benchmark
Ametek (AME) improved its Investor’s Business Daily Relative Strength rating from 80 to 84, crossing the 80‑point threshold that historically precedes strong price rallies. The company reported sales growth of 13% year‑over‑year, while earnings margin fell from 14% to 7%...

Quanex Building Products Earns Technical Rating Upgrade
Quanex Building Products (NX) saw its Investor’s Business Daily Relative Strength rating climb from 70 to 77, signaling improved price momentum. The upgrade places the stock closer to the 80‑plus threshold that historically precedes strong uptrends. Meanwhile, the company reported...

Construction Ptrs Cl A Sees IBD RS Rating Improve To 72
Construction Ptrs Cl A (ROAD) saw its Investor's Business Daily Relative Strength rating jump from 64 to 72, edging closer to the 80‑plus level that historically precedes strong price moves. The stock is in a consolidation pattern with an entry...

Stocks Flashing Renewed Technical Strength: LATAM Airlines Group ADR
LATAM Airlines Group ADR saw its Investor's Business Daily Relative Strength rating jump to 84, up from 77. The rating places the stock in the top 20% of performers over the past 52 weeks. Quarterly earnings growth accelerated dramatically to...

What Stock Market Values More? Nithin Kamath of Zerodha Flags a Paradox Investors Can’t Ignore
Zerodha co‑founder Nithin Kamath highlighted a valuation paradox in India, noting that financial firms often command higher market capitalisations than essential healthcare providers such as Narayana Hospitals. Narayana, with about 18,000 beds, is valued at roughly ₹38,000 crore, yet many brokerages trade...

Toyota Motor ADR Sees Relative Strength Rating Climb To 73
Toyota Motor ADR’s Investor’s Business Daily Relative Strength rating jumped from 68 to 73, indicating a notable uptick in price momentum over the past year. The move places the stock closer to the 80‑point threshold that often precedes strong gains,...

TCS Q4 Results 2026 LIVE: Net Profit Jumps 12% YoY to ₹13,718 Crore, Revenue up 9.6%
Tata Consultancy Services reported a 9.6% year‑on‑year revenue increase to ₹70,698 crore for Q4 FY26, while net profit rose 12% to ₹13,718 crore. Operating margin improved to 25.3%, the highest in four years, and AI‑related revenue topped $2.3 billion. The company disclosed a...

TCS Q4 Results 2026 Date Today: Time, Preview, Key Expectations You May Like to Know
Tata Consultancy Services will announce its FY 2025‑26 Q4 results on April 9 after‑market, following a 28 % share plunge in the March quarter – the steepest decline since 2008. Analysts expect modest revenue growth of 6‑8 % YoY to about ₹69,600 crore and a...

3 Top Small-Cap Growth Mutual Funds for Outstanding Returns
Small‑cap growth mutual funds, which target companies under $2 billion, are gaining attention for their high‑risk, high‑reward profile. Zacks highlights three top‑ranked funds—Emerald Growth (HSPGX), T. Rowe Price Integrated US Small‑Cap Growth Equity (PRDSX), and Northern Small Cap Core Fund (NSGRX)—each holding...

Beyond Mitigation: What Can Ongoing Emissions Responsibility Fund?
Beyond mitigation, companies are urged to adopt Ongoing Emissions Responsibility (OER), a framework that holds them accountable for residual Scope 1‑3 emissions while transitioning to net‑zero by 2050. OER expands corporate climate action to include non‑mitigation investments such as policy advocacy,...

Gold, Silver Rate Today, 9 April: Check Live Price of 24 Kt, 22 Kt, 18 Kt Gold and 10 Gm,...
Gold and silver prices in India slipped on 9 April as investors grew cautious amid rising crude‑oil prices following the Israel‑Lebanon clash. MCX gold opened at a downside gap of ₹1,50,647 per 10 gm but recovered above ₹1,51,000, ending 0.5% lower than...

Oil Shock, AI Tailwinds, and Portfolio Shifts Across Emerging Markets>
Emerging‑markets investors faced a sharp near‑term shock as the Middle East conflict drove Brent crude above $100 a barrel, tightening current‑account balances for oil‑importing economies while boosting exporters. Despite the volatility, the fund retained confidence in long‑term AI‑driven supply‑chain and...

Is PropTech The Real Solution for Housing Affordability? Insights From Tyler Ashby, Partner at GroundBreak Ventures
In this episode, hosts Aaron Cameron and Adam Pawatik interview Tyler Ashby, a partner at Groundbreak Ventures, about the role of PropTech in tackling housing affordability. Ashby explains his transition from construction engineering to venture capital, the origins and focus...

Holding Nifty 23600 CE Until IV Drops Below 10
Holding Nifty 13 Apr 23600 CE. Risky trade given elevated premiums, though IV has cooled to ~16. Still not cheap. Plan is simple. Holding as long as IV stays above 10. Any further crush and I’ll look to roll over to the...

Investwise's Dave Quinn Explains Ireland's New Investment Scheme
Back by popular demand, Dave Quinn from Investwise joins Mike on Stock Club to break down Ireland's new investment scheme.... https://t.co/p8PyRws8SM

Today's Earnings: Pre‑Open BB, SMPL, NEOG, BYRN; Post‑Close WDFC, S
#earnings for today (Thursday): Before Open: $BB $SMPL $NEOG $BYRN After Close: $WDFC $SLP https://t.co/vKBB8Cb9GD